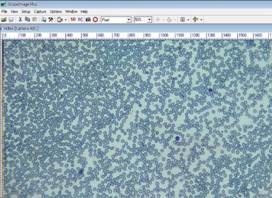

К.тех.н.
Думенко В.П.
Цмуз
Т.П.
Вінницький
державний педагогічний університет імені Михайла Коцюбинського, Україна
Фізичне
моделювання і дослідження зміни реологічних властивостей крові
Раннє виникнення мікрореологічних розладів крові,
що може приводити до порушення кровотоку в
системі мікроциркуляції, яка приймає на себе перший удар при
виникненні патологічного процесу, і сприяє прогресуванню морфологічних ознак
захворювання.
Тому виявлення мікрореологічних змін на перших стадіях
захворювання може бути його найпростішою діагностикою. Зміна властивостей еритроцитів спостерігається при багатьох
захворюваннях серцево-судинної системи, крові, цукровому діабеті, хірургічній
патології [4-5].
В'язкість
крові залежить, головним чином, від концентрації еритроцитів і менше - від
концентрації білків плазми. Вона залежить також від швидкості течії крові. Якщо
швидкість течії крові зменшується, еритроцити збираються в специфічні
скупчення, так звані "монетні стовпчики". Це призводить до підвищення
в'язкості крові. Такий феномен можна спостерігати в дрібних кровоносних
судинах, де швидкість течії крові невелика.
Для
опису впливу на реологічні властивості крові патологічних змін, викликаних
різноманітними захворюваннями необхідно застосувати реологічну модель. Кров
моделюють як суспензію недеформованих
твердих частинок у лімфі. Закономірності
руху такої модельної рідини в судинах випадку стаціонарного руху крові в
судинах круглого перерізу описуються законом Пуазейля.
![]() (1)
(1)
де l — довжина судини.
Середня
швидкість руху крові по судинах виражається:
![]() (2)
(2)
Величина
коефіцієнта опору:
![]() (3)
(3)
![]() (4)
(4)
Формула (4) є виражає закон
опору ламінарного руху в’язкої рідини в циліндричній судині [1-2].
Реологічні
властивості, зокрема в’язкість крові
визначається швидкість руху крові та агрегаційними властивостями еритроцитів.
В’язкість з фізичної точки зору визначається формулою Ньютона:
![]() , (5)
, (5)
При цьому коефіцієнт в’язкості крові буде визначатися формулою і
концентрацією еритроцитів:
![]() (6)
(6)
де К – геометричний фактор, який залежить від форми і розмірів
еритроцитів, С – концентрація еритроцитів.
Геометричний фактор К буде змінюватись в залежності від руху крові
в великих судинах і в капілярах і здатності еритроцитів до агрегації.
Було проведено експериментальні
дослідження мікрореологічних змін при захворюванні цукрового діабету оптичними
методами.
В експериментальних дослідженнях
використовувались зразки крові у вигляді мазків. Приготування і зафарбовування
зразків робили таким чином: на чистому
знежиреному предметному скельці утворюють мазок
капілярної крові, розмащують краплю під кутом 45°, залишають до
висихання. Після цього протилежно від краплі проводять смугу ребром скла, мазок
повинен бути напівпрозорим і закінчуватися нерівностями. Після висихання мазок
фіксують фарбою Май-Грюнвальда протягом 3 хвилин, щоб запобігти руйнуванню форменних
елементів. Зафіксовані сухі мазки
фарбують за Романовським.

а)
б)
Рис.1.
а) зразок капілярної крові із діагнозом
цукровий діабет; б) зразок капілярної крові здорових людей.
Результати досліджень свідчать, що середнє число еритроцитів в
ланцюжку в крові здорових людей становить 5±2 еритроцитів, а при захворюванні
цукрового діабету збільшується до 14±2.
Отже, при діагнозі – цукровий діабет змінюються реологічні властивості
крові.
Список використаних
джерел:
1.
Вервейко Н.Д., Сумец
П.П., Воронкова А.А. Математическая модель пульсового движения крови в сосудах
// Вестник Воронежского государственного университета. — 2003. — № 3.
2.
Djordjevic Vladan D. On
the fluid flow over a compliant wall // Facta Univ. Ser. Mech., Autom. Contr.
and Rob. Univ. Nis. — 2000.
3.
Педли Т. Гидродинамика
крупных кровеносных сосудов: Пер. с англ. — М.: Мир, 1983.
4.
Гущин А.Г.,
Муравьев А.В., Шаечкина
И.К. Оценка комплекса
гемореологических параметров при эритроцитозе //
Физиология человека. – 2000. – Т. 26. – № 2. – С. 111–114.
4. Катюхин Л.Н.
Реологические свойства
эритроцитов. Современные
методы исследования // Российский
физиологический журнал им.
И.М. Сеченова. – 1995. – Т. 81, №
6. – С. 122–129.
5. Cotran
R.S., Kumar V., Collins T. Pathologic basis of disease //
W.B. Saunders Company Philadelphia. –
London N.Y., 2004, 1426.